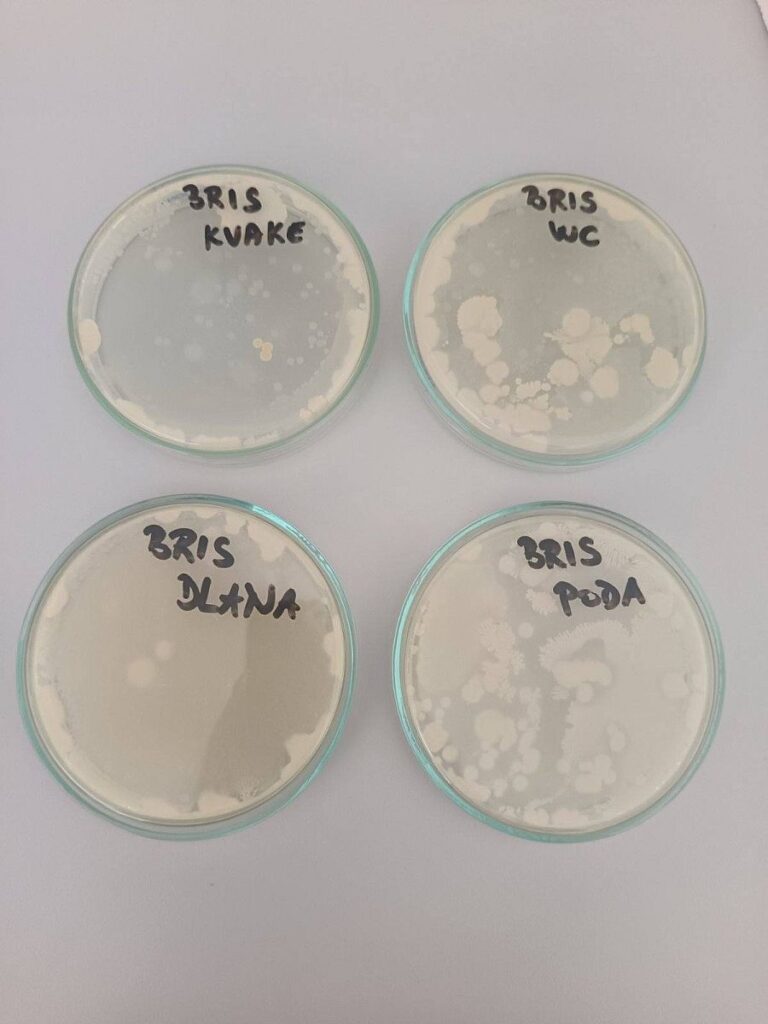

Znanost u fokusu – istraživanje, kreativnost i suradnja

U Poljoprivredno-prehrambenoj školi Požega obilježili su Svjetski dan znanosti za mir i razvoj. Ovi dani podsjećaju koliko su znatiželja, istraživanje i kreativnost važni u svakodnevnom životu, te kako znanost povezuje ljude, ideje i kulture, poručili su.
Mikrosvijet pod povećalom
Profesorica Dijana Garbin s učenicima trećeg razreda – prehrambenim tehničarima – provela je laboratorijske vježbe u kojima su istraživali „živi svijet u kapljici vode“. Mikroskopirali su uzorke barske i riječne vode, proučavali zooplanktone i fitoplanktone te zaključili da barska voda krije bogatiji i raznolikiji biljni i životinjski svijet.
Učenici su također pripremali hranljivu podlogu od agara i uzgajali mikroorganizme s brisa usne šupljine, poda i dlana. Nakon inkubacije analizirali su kolonije i uspoređivali njihovu brojnost, približavajući se fascinantnom svijetu mikrobiologije.
Znanost i društvo – debata o digitalnom dobu
Profesorica Anita Bubak organizirala je debatno natjecanje za učenike četvrtog razreda – agroturističke tehničare – na temu utjecaja digitalnih platformi i društvenih mreža na političke stranke. Učenici su istraživali temu, pripremali govore i pitanja te pokazali zavidno znanje i kritičko razmišljanje o povezanosti tehnologije, medija i politike.
Žiri u sastavu profesorica Monika Bonić, Ivana Škrabal i Dijana Garbin pohvalio je trud i pripremljenost svih sudionika. Pobjedu je odnijela ekipa koja je zastupala stav „ZA“, a svi su završetak debate proslavili u vedrom duhu i uz slatku nagradu.
Lice znanosti – kreativni izrazi
Kako bi obilježavanje Svjetskog dana znanosti za mir i razvoj bilo vidljivo svima, profesorica Ivona Bećirivić izradila je plakat „Lice znanosti“ kombinirajući crtanje i kolaž tehniku, dok je profesorica Anita Bubak s učenicima pripremila pano posvećen ovom danu. Oba rada izložena su u školskom holu, potičući kreativnost i promišljanje učenika.
Spoj znatiželje, istraživanja i inovacije
Ovogodišnje obilježavanje pokazalo je koliko su učenici spremni istraživati i stvarati. Bilo kroz mikroskopska istraživanja, debate ili kreativni izražaj – znanost i inovacija su svuda oko nas i potiču nas da promatramo, razumijemo i mijenjamo svijet.
Tekst i foto: A. B., D. G., i I. B.